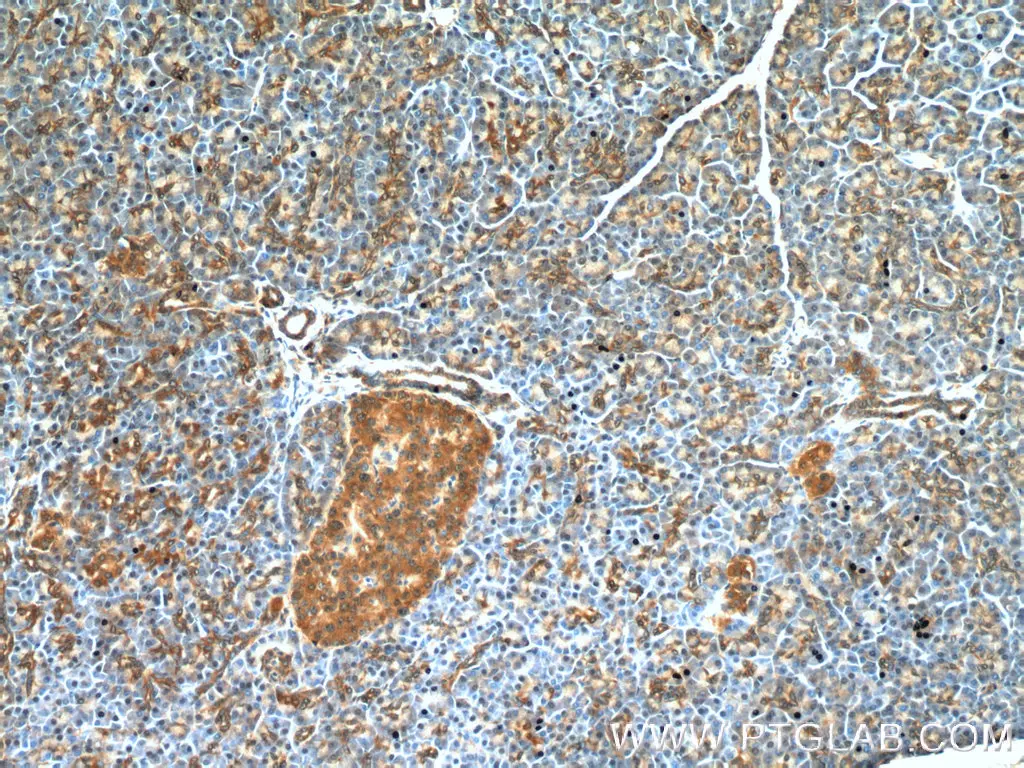

Non-Apoptotic Cell Death
Introduction
While apoptosis is the earliest discovered and most extensively studied cell death pathway, several non-apoptotic cell death pathways have gained significant attention in recent years due to their potential in cancer therapy and their involvement in the pathogenesis of multiple diseases. Any cell death pathway that is characterized by the absence of typical morphological hallmarks of apoptosis, including chromatin condensation, nuclear fragmentation, and membrane blebbing, and is not mediated by the apoptotic caspases can be classified as non-apoptotic cell death. Some of the most widely studied non-apoptotic cell death pathways include ferroptosis, pyroptosis, and necroptosis.
Proteintech offers a wide range of products to help you with your non-apoptotic cell death research.
Contents: |
Ferroptosis
Ferroptosis is an iron-dependent form of regulated cell death characterized by an increase in intracellular reactive oxygen species (ROS) levels. The primary morphological hallmark of ferroptosis is a decrease in mitochondrial volume accompanied by a loss of mitochondrial cristae, which is typically not seen in other cell death pathways.
The peroxidase GPX4, whose activity relies on glutathione (GSH) biosynthesis, is a key regulator of the ferroptosis pathway. GPX4 utilizes GSH as a cofactor to reduce intracellular lipid peroxides. Inactivation of GPX4 caused by intracellular GSH depletion leads to ROS accumulation, thereby triggering ferroptosis. Ferroptosis can also be regulated by the cell surface cysteine-glutamate antiporter (system xc-) consisting of SLC7A11 and SLC3A2 in conjunction with the glutathione metabolic pathway. Inhibition of system xc- prevents glutathione synthesis by inhibiting cysteine absorption, leading to oxidative stress and impairment of GPX4 activity, which in turn promotes ferroptosis.
Transferrin receptor plays a crucial role in ferroptosis by regulating the cellular uptake of iron, which then mediates the peroxidation of lipids via Fenton reactions leading to the induction of ferroptotic cell death. Recently, several GPX4-independent pathways including the FSP1-CoQ10 pathway and the ESCRT-III-dependent membrane repair pathway have been shown to be involved in the regulation of ferroptosis.

Related products
| GPX4 | CHAC1 | SLC7A11/xCT |
| FSP1 | CBS | NOX1 |
| KEAP1 | COX2 | Transferrin receptor |
| NRF2 | DMT1 | HO-1 |
| CD98/SLC3A2 | GSS | Ferritin light chain |


Pyroptosis
Pyroptosis is an inflammatory form of regulated cell death that has gained considerable attention in recent years due to its association with multiple diseases and as an effective approach for treating cancers. Pyroptosis typically proceeds through either the canonical pathway or the non-canonical pathway. In the canonical pathway, recognition of pathogenic stimuli by intracellular pattern recognition receptors results in inflammasome assembly and the consequent activation of caspase-1 leading to gasdermin D (GSDMD) cleavage and the release of the inflammatory cytokines, IL-1β and IL-18.
The non-canonical pyroptotic pathway is induced by LPS derived from gram-negative bacteria, which in turn activates caspase-11 in mice or caspase4/5 in humans leading to GSDMD cleavage and subsequent pyroptotic cell death. Activated caspase-11 also causes secondary activation of the NLRP3 inflammasome resulting in IL-1β and IL-18 release.

Related products
| ASC | GSDMB | IL-1 Beta |
| Caspase-1 | GSDMD | IL-18 |
| Caspase-4 | GSDME | NLRP3 |


Necroptosis
Necroptosis is a form of regulated necrotic cell death pathway that can be initiated by various factors including TNF superfamily receptors, pattern recognition receptors, T cell receptors, environmental stress, and chemotherapeutic agents. Necroptosis has been implicated in the pathogenesis of several inflammatory diseases including inflammatory bowel disease, atherosclerosis, sepsis, rheumatoid arthritis, and cardiac ischemia. Necroptosis has also been associated with several neurodegenerative, autoimmune, and infectious diseases.
Of the above-mentioned factors, necroptosis mediated by TNFα and its receptor TNFR1 is the most well-characterized pathway. In this pathway, binding of TNFα to TNFR leads to the assembly of a multimeric protein complex consisting of TRADD, TRAF2/5, cIAP, and RIP1. RIP1 plays a critical role in determining cell fate by committing cells to either cell survival or cell death pathways. While polyubiquitination of RIP1 by cIAP1/2 activates the NF-κB cell survival pathway, inhibition of RIP1 ubiquitination leads to the activation of either apoptotic or necroptotic cell death pathways. The association of RIP1 with FADD and procaspase-8 results in apoptotic cell death by caspase-8 activation and subsequent RIP1 cleavage. In the absence of caspase-8 activation, RIP1 associates with RIP3 to form the necrosome. The necrosome then phosphorylates MLKL leading to its oligomerization and subsequent insertion into the plasma membrane. Membrane insertion of MLKL results in cell rupture and the release of inflammatory molecules such as DAMPs into the extracellular space.

Related products
| DR5 | FLIP | TRADD |
| FADD | RIPK1 | TRAF2 |
| FAS | TNFR1 | TRAIL |
| MLKL | RIPK3 | Caspase 8 |